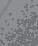

Поларна станишта Арктика, на крајњем северу Земље, као и Антарктика, на крајњем југу, веома су негостољубива места за живи свет. Мада су покривене снегом и дебелим ледом, те ужасно хладне области настањене су чудесним животињама. Штитећи се од зиме дебелим крзном,

























Lydia Halliday, Amanda Shufflebotham, SEEK & FIND. SEARCHLIGHT. ANIMALS
Copyright © 2025 Gemini Childrens Books Ltd, part of Gemini Books Group.
